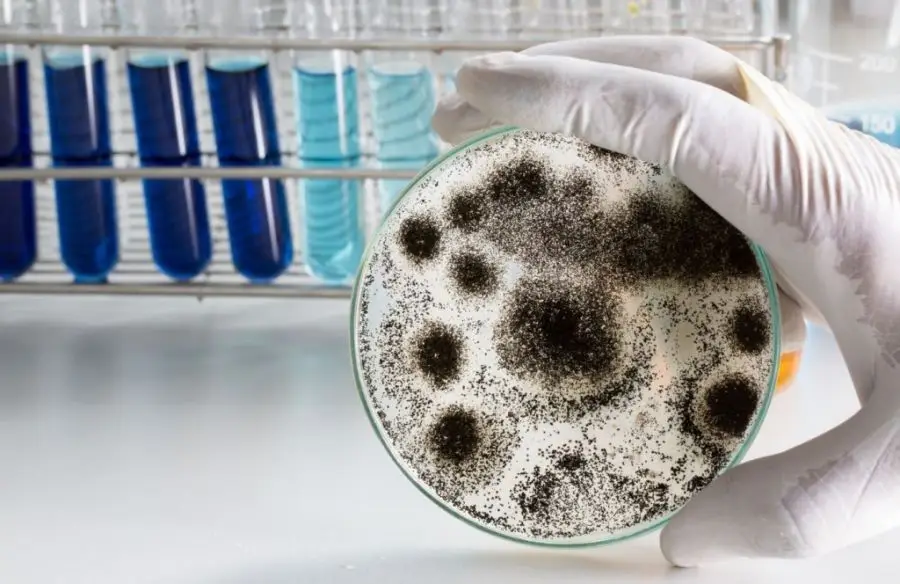

พฤติกรรมเสี่ยงต่อการเป็นเชื้อราในร่างกาย
พฤติกรรมการซักผ้าของคนสมัยนี้ ชอบซักผ้ากันตอนกลางคืน ซึ่งเป็นเวลาหลังเลิกงาน ซึ่งเวลานี้จะได้รับแค่ลมที่ทำให้ผ้าแห้ง ซึ่งเป็นสาเหตุหนึ่งที่มีผลทำให้ผ้าเกิดการอับชื้น มีกลิ่นไม่พึงประสงค์ ที่ร้ายแรงกว่านั้นเสื้อผ้าที่มีลักษณะอับชื้น เมื่อคุณได้สวมใส่ จะทำให้เพื่อนๆเสี่ยงต่อการเป็นเชื้อราตามส่วนต่างๆของร่างกาย
วิธีจัดการเสื้อผ้าอย่างไรไม่ให้เกิดเชื้อรา?
– เราควรนำเสื้อผ้าไปซักที่ เครื่องซักผ้า พร้อมปั่นแห้ง และนำไปตากแดดให้แห้งสนิท เพราะแสงแดดสามารถฆ่าเชื้อราได้ หากเพื่อนๆซักผ้าตอนกลางคืน ในตอนเช้าก็ให้เพื่อนๆนำเสื้อผ้าที่ซักไปตากแดดซ้ำอีกครั้ง
– นอกจากนี้เราควรนำเสื้อผ้าที่ซักแล้วที่อยู่ในตู้โดยเฉพาะชุดชั้นในออกมาพึ่งแดดสัปดาห์ละ 1 – 2 ครั้งเพื่อลดความเสี่ยงต่อการเกิดเชื้อรา
– อย่าหมักหมมเสื้อผ้าไว้ในตะกร้าเป็นเวลานาน ให้นำไปซักทำความสะอาด และห้ามนำกลับมาใช้ซ้ำโดยเด็ดขาด
– หากเพื่อนๆเป็นเชื้อราแล้ว ควรรีบปรึกษาแพทย์ เพราะหากซื้อยาผิดมาใช้ ซึ่งบางชนิดที่มีส่วนผสมของสเตียรอยด์จะบรรเทาอาการได้เพียงชั่วคราวเท่านั้น เมื่อยาหมดฤทธิ์แล้ว แผลจะขยาดเพิ่มมากขึ้นกว่าเดิม ซึ่งยาที่มีส่วนผสมสเตียรอยด์ จะยิ่งทำให้ภูมิคุ้มกันเชื้อราลดลง ทำให้เพื่อนๆเป็นเชื้อราได้ง่ายขึ้นกว่าเดิม
ห้างสรรพสินค้าในประเทศไทย ที่มีขนาดใหญ่มากจนคนมักจะหลงทาง
คนสนใจหลายเรื่องอาจไม่ได้หลงทาง รู้จักกรอบคิดแบบ M-Shaped
5 จังหวัด ที่เจองูกะปะเยอะที่สุดในประเทศไทย
108 ท่าบนเตียง มีอะไรบ้าง Sex position ท่าเด็ดบนเตียง
ทำไมฝาขวดน้ำยุคใหม่ถึงไม่หลุดจากขวด? เรื่องเล็กที่หลายคนหงุดหงิด แต่มีเหตุผลซ่อนอยู่
5 จังหวัดที่มีงูเยอะที่สุดในประเทศไทย
10 มอเตอร์ไซค์ไฟฟ้าที่คนไทยเริ่มสนใจ ก่อนเปลี่ยนจากรถน้ำมัน
7 วิธีเพิ่มคุณค่าในตัวเอง แบบไม่ต้องเรียกร้องให้ใครเห็นค่า
5 หนังที่ถูกปฏิเสธเรตในอังกฤษ เพราะเนื้อหารุนแรงเกินขอบเขต
ใครสังหาร ฟาโรห์รามเสสที่ 3
ผลตรวจ DNA ยืนยัน เด็กในครรภ์ของ “ฟารีดา” เป็นลูกของ “ติณติณ” ปิดฉากทุกข้อสงสัย
รถยนต์ไฮบริดไทย ปี 2026 รุ่นไหนบ้างที่ประหยัดน้ำมันสุดๆ
ห้างสรรพสินค้าไทยที่หรูหรามาก จนหลายคนไม่กล้าเข้าไปเพื่อใช้บริการ